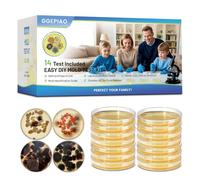
Mold Test Kit for Home - 7 Simple Detection Tests,Test HVAC System,Home Surfaces,& Indoor Air Quality Testing Kits,DIY Mold Detector at Home,Includes Detailed Mold Identification Guide (14)

£20.79
Amazon-marketplace.co.uk
Free Delivery

£359.11
Amazon-marketplace.co.uk
Free Delivery

£135.72
Amazon-marketplace.co.uk
Free Delivery

Mold Test Kit for Home - 8 Simple Detection Tests for HVAC, Surfaces & Indoor Air Quality, DIY Black Mold Detector Testing kit at Home, with Detailed Identification Guide & 5X Magnifying Glass
£31.77
Amazon-marketplace.co.uk
Free Delivery

Mold Test Kit for Home Testing: 12 Counts DIY at Home Mold Test for Air Quality Object Surface and HVAC Indoor Detect Black Mold and More
£20.08
Amazon-marketplace.co.uk
Delivery from £8.12

anlab™Mold Test Kit for Home - Do It Yourself Home Mold Detector | Test HVAC System | Home Surfaces | Indoor Air Quality Testing Kit - Identification Guide Included - Sealed Separately (Items of 9)
£29.89
Amazon-marketplace.co.uk
Free Delivery

Air Quality Tester ,Temperature and Humidity Real time Display Mold Test Kit for Home for Bedroom for Home(black)
£25.09
Amazon-marketplace.co.uk
Free Delivery

anlab™Mold Test Kit for Home - Do It Yourself Home Mold Detector | Test HVAC System | Home Surfaces | Indoor Air Quality Testing Kit - Identification Guide Included - Sealed Separately (Items of 3)
£22.71
Amazon-marketplace.co.uk
Free Delivery

Air Quality Tester mold test Clear Number Mold Test Kit mold sensor meter for Home for Bedroom for Home(White) Electrical Multimeters
£37.99
Amazon-marketplace.co.uk
Free Delivery

Mold Test Kit for Home, Temperature and Humidity Mold Detector, Air Quality Monitor Real Time Wide Range Of Applications, Formaldehyde Detector for Bedroom for Home(black)
£25.09
Amazon-marketplace.co.uk
Free Delivery

Mold Test Kit for Home-6 Simple Detection Tests,Test HVAC System,Home Surfaces,Indoor Air Quality Testing Kits,DIY Black Mold Detector at Home,Includes Detailed Mold Identification Guide
£19.68
Amazon-marketplace.co.uk
Delivery from £7.09

Mold Test Kit for Home - 8 Simple Detection Tests for HVAC, Surfaces & Indoor Air Quality, DIY Black Mold Detector Testing kit at Home, with Detailed Identification Guide & 5X Magnifying Glass
£21.89
Amazon-marketplace.co.uk
Delivery from £8.55

Mold Test Kit for Home-6 Simple Detection Tests,Test HVAC System,Home Surfaces,Indoor Air Quality Testing Kits,DIY Black Mold Detector at Home,Includes Detailed Mold Identification Guide
£19.99
Amazon-marketplace.co.uk
Free Delivery

Mold Test Kit for Home - 7 Simple Detection Tests,Test HVAC System,Home Surfaces,& Indoor Air Quality Testing Kits,DIY Mold Detector at Home,Includes Detailed Mold Identification Guide (14)
£41.76
Amazon-marketplace.co.uk
Free Delivery

anlab™Mold Test Kit for Home - Do It Yourself Home Mold Detector | Test HVAC System | Home Surfaces | Indoor Air Quality Testing Kit - Identification Guide Included - Sealed Separately (Items of 6)
£32.08
Amazon-marketplace.co.uk
Free Delivery

Mold Test Kit for Home - 7 Simple Detection Tests,Test HVAC System,Home Surfaces,& Indoor Air Quality Testing Kits,DIY Mold Detector at Home,Includes Detailed Mold Identification Guide (14)
£47.04
Amazon-marketplace.co.uk
Free Delivery

Home Shape Test Kit - 7 Easy Detection Tests, Test HVAC System, Home Surfaces and Indoor Air Quality Test Kits, DIY Shape Detector at Home, Includes Detailed
£26.92
Amazon-marketplace.co.uk
Free Delivery

anlab™Mold Test Kit for Home - Do It Yourself Home Mold Detector | Test HVAC System | Home Surfaces | Indoor Air Quality Testing Kit - Identification Guide Included - Sealed Separately (Items of 3)
£13.99
Amazon-marketplace.co.uk
Delivery from £4.49

anlab™Mold Test Kit for Home - Do It Yourself Home Mold Detector | Test HVAC System | Home Surfaces | Indoor Air Quality Testing Kit - Identification Guide Included - Sealed Separately (Items of 3)
£20.62
Amazon-marketplace.co.uk
Free Delivery

Home Shape Test Kit - 7 Easy Detection Tests, Test HVAC System, Home Surfaces and Indoor Air Quality Test Kits, DIY Shape Detector at Home, Includes Detailed
£26.06
Amazon-marketplace.co.uk
Free Delivery

Supreme - DIY Mold Test Kit for Home Air Quality - Air and Surface Mold Testing - Pre-Paid Return Mailer and Expert Mold Consultation - Optional Lab Analysis
£15.14
Amazon-marketplace.co.uk
Delivery from £6.43

Home Shape Test Kit - 7 Easy Detection Tests, Test HVAC System, Home Surfaces and Indoor Air Quality Test Kits, DIY Shape Detector at Home, Includes Detailed
£25.30
Amazon-marketplace.co.uk
Free Delivery

Mold Test Kit with 4 Individual Tests - DIY Mold Test Kit for Home - Includes Detailed Mold Identification Guide - Fast Mold Detector and
£17.57
Amazon-marketplace.co.uk
Delivery from £6.99

Mold Test Kit for Home, Mold Air Test Kit for Home, Mold Test Kit 48 Hours Results, Mold Detector Tests HVAC Systems and Air Quality, Black Mold Testing Kit Includes Mold Identification Guide(10pcs)
£24.95
Amazon-marketplace.co.uk
Delivery from £7.04

Evviva Sciences Mold Test Kit for Home - 10 Simple Mold Detection Tests - Optional Lab Analysis - Test HVAC System, Room Air, & Home Surfaces for Molds/Spores - Includes Detailed Mold ID Guide
£49.75
Amazon-marketplace.co.uk
Delivery from £7.76

Mold Test Kit with 4 Individual Tests - DIY Mold Test Kit for Home - Includes Detailed Mold Identification Guide - Fast Mold Detector and
£24.99
Amazon-marketplace.co.uk
Free Delivery

anlab™Mold Test Kit for Home - Do It Yourself Home Mold Detector | Test HVAC System | Home Surfaces | Indoor Air Quality Testing Kit - Identification Guide Included - Sealed Separately (Items of 9)
£31.50
Amazon-marketplace.co.uk
Free Delivery

Mold Test Kit for Home - 7 Simple Detection Tests,Test HVAC System,Home Surfaces,& Indoor Air Quality Testing Kits,DIY Mold Detector at Home,Includes Detailed Mold Identification Guide (14)
£44.51
Amazon-marketplace.co.uk
Free Delivery

anlab™Mold Test Kit for Home - Do It Yourself Home Mold Detector | Test HVAC System | Home Surfaces | Indoor Air Quality Testing Kit - Identification Guide Included - Sealed Separately (Items of 6)
£27.00
Amazon-marketplace.co.uk
Free Delivery

Mold Test Kit for Home Testing: 6 Counts DIY at Home Mold Test for Air Quality Object Surface and HVAC Indoor Detect Black Mold and More
£17.23
Amazon-marketplace.co.uk
Delivery from £6.75

Mold Test Kit with 4 Individual Tests - DIY Mold Test Kit for Home - Includes Detailed Mold Identification Guide - Fast Mold Detector and
£24.56
Amazon-marketplace.co.uk
Free Delivery

Mold Test Kit with 4 Individual Tests - DIY Mold Test Kit for Home - Includes Detailed Mold Identification Guide - Fast Mold Detector and
£29.51
Amazon-marketplace.co.uk
Free Delivery

Healthful Home® 5-Minute Home Mold Test (Aspergillus, Penicillium, Stachybotrys)
£43.99
Amazon-marketplace.co.uk
Free Delivery

anlab™Mold Test Kit for Home - Do It Yourself Home Mold Detector | Test HVAC System | Home Surfaces | Indoor Air Quality Testing Kit - Identification Guide Included - Sealed Separately (Items of 9)
£37.19
Amazon-marketplace.co.uk
Free Delivery
Mold Test Kit for Home - 7 Simple Detection Tests,Test HVAC System,Home Surfaces,& Indoor Air Quality Testing Kits,DIY Mold Detector at Home,Includes Detailed Mold Identification Guide (14)
£41.76
Amazon-marketplace.co.uk
Free Delivery

Mosynex - Home Mold Test Kit, 6 Detection Tests, Black Mold Detector Test Kit, Indoor Air Quality Testing for HVAC Systems and Surfaces, Analysis
£36.16
Amazon-marketplace.co.uk
Free Delivery

For Mold Test Kit For Home, 10 Simple -Mold Detection Tests, Optional Lab Analysis, Test HVAC System, Room Air, Home Surfaces For Molds
£18.39
Amazon-marketplace.co.uk
Free Delivery

Home Shape Test Kit - 7 Easy Detection Tests, Test HVAC System, Home Surfaces and Indoor Air Quality Test Kits, DIY Shape Detector at Home, Includes Detailed
£28.12
Amazon-marketplace.co.uk
Free Delivery

Home Shape Test Kit - 7 Easy Detection Tests, Test HVAC System, Home Surfaces and Indoor Air Quality Test Kits, DIY Shape Detector at Home, Includes Detailed
£26.31
Amazon-marketplace.co.uk
Free Delivery

Mold Test Kit for Home - 7 Simple Detection Tests,Test HVAC System,Home Surfaces,& Indoor Air Quality Testing Kits,DIY Mold Detector at Home,Includes Detailed Mold Identification Guide (14)
£44.45
Amazon-marketplace.co.uk
Free Delivery
- 1
- 2
- 3
- 4
- next page
🤖 Ask ChatGPT
🛍️ What are the most important purchase criteria?
💰 Tell me the best deals!
📋 Create a short summary!
Informations about "air mold test"
Having searched the market for the cheapest prices of sale, 160 bids were found for comparison.
Furthermore, a large number of article in 5 relevant categories with a price range from £2.73 to £623.95 were found.
About "air mold test"
- Overall, our search showed 4 different online stores for your product "air mold test", including Amazon-marketplace.co.uk, bikeinn.com (UK), amazon.co.uk and snowinn.com (UK).
- After having chosen your companies you may also choose the delivery company. 9 delivery companies are available BRN, Rudy Project, Urban Armor Gear and Rainberg being the most popular.
- The most bids (14) were found in the price range from £38.00 to £38.99.
- Furthermore, other users were also interested in the following product: .
- Personalise your product by choosing one of the 0 shades.
Don't forget your voucher code:
Report Illegal Concerns
You are about to report a violation based on the EU Digital Services Act (DSA).